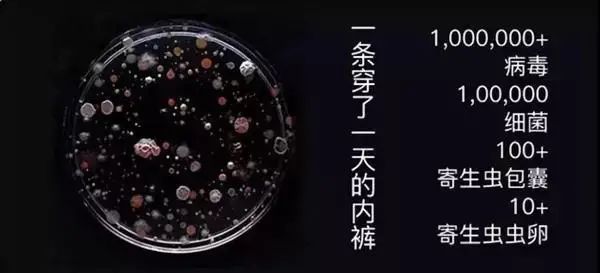

对于我这种不爱做家务的懒癌来说,
洗衣机、洗碗机和扫地机,
简直是我的生命之光。
但我最近发现一款内衣裤洗衣机,
直接让我开心到原地升天!
一台机器,只要配上几个洗涤袋,
就可以清洗全家的内衣裤、袜子,
和手洗一样干净,瞬间解放双手!

新家伙到手已经2个月了,
感受就俩字:真香!
想要不出一分力,
还能天天换上像是用双手揉搓过的,
干净卫生、高温消毒过的内裤、袜子……
醒醒醒醒,真的有这等美事儿!


文字已经不能表达我激动的心情,
想快速了解这个能带来幸福感的小家伙,
建议你们先戳这个视频简单了解一下。
既然本质是洗衣机,
肯定有人会问:
“机器能有手洗的干净吗?”
我们先上结果——

▲女士内裤清洗前后实拍

▲小朋友内裤清洗前后实拍
右滑高能预警!
>
▲沾了姨妈血的内裤清洗前后实拍
看到这里,
应该有不少妹子or妈妈动心了吧?
毕竟我们每天吭哧吭哧在水池旁边忙活半天,
也不见得能洗得比这再干净了。

看了结果之后,
我们再来看看这台洗衣机,
为什么能把衣物洗这么干净?
原理又是什么?


一般的内衣裤洗衣机,
洗涤方式是这样的——
(其实就是缩小版的滚筒洗衣机)
左搅搅右搅搅,干不干净看天意。

而觉飞内衣裤洗衣机,
洗涤方式是这样洗的——

这是觉飞历时4年研发的——
softscrub仿手洗专利技术,
整个过程完美还原了手搓过程。
看个慢动作,
这不就是我每天用双手在做的事儿嘛。

硅胶洗涤袋的两侧有两个小爪爪,
就像一双柔软灵巧的双手,
360°无死角地滚动揉搓内裤,
机器工作一次就会搓洗2160下,
相当于手洗18分钟!
(相信你们谁洗一条内裤也不会洗到18分钟吧)

而且它很智能的是,
洗涤袋里装的内容不一样,
东西多少不一样,搓洗力度也会不同,
洗干净的同时还能保护面料,
洗完也不易使衣物变形,爱了爱了。


此外,这款洗衣机还贴心的设计了——
可换洗的衣物袋,
能将内衣裤和袜子分开清洗。
一人一袋,专人专用,更加干净卫生。


它共有3种清洗模式,
高温煮洗、温水速洗和常温净洗,
能满足不同的清洗需求,
对白色念珠菌、金黄葡萄球菌、大肠杆菌等——
杀菌率都高达99.99%。

▲检测报告
还有医务工作者买回家后,
赶紧做了个实验后表示:
内裤像从洗消锅里拿出来的一样,
无菌得让人安心。

如果你是忙得没空做家务的打工人、
或是辛苦带娃的宝妈、想疼妻子的丈夫,
我劝你下手别犹豫!
提升全家幸福感全靠它!

01
一人一袋,一物一袋
轻松搞定全家人贴身衣物
眼尖的小伙伴肯定已经发现了,
觉飞内衣裤洗衣机只有一个缸,
你告诉我能洗内裤、洗裤子、洗bra?
难道让我洗完内裤再洗bra吗?
或者是给老公洗完臭袜子再给孩子洗内内吗?

别说全家人的贴身衣物在清洗时不能一起洗,
就算是自己的袜子和内裤,
也不可能放在一起洗啊。

内裤上的尿渍、
粪汁和袜子里的真菌、
角质混在一起造作,
很可能导致股藓等皮肤病。

有宝宝的家庭就更得谨慎了,
小朋友抵抗力弱,
贴身衣物和大人一起混洗,
还可能有被感染的风险。
混洗是绝不可能的,
如何在健康和实(jia)用(ge)之间找到一个平衡点?
机智的研发团队独创了换袋清洗的设计。

一人一袋,一物一袋,
洗涤袋的材质是健康环保的食品级硅胶,
无毒无害,手感超赞,
容量也hin可观——
有1.5L,一袋最多可以洗:
3条内裤/3双袜子/1件无钢圈的内衣。
(当然,我建议一件一洗,
贴身衣物最重要的就是脱下来可以随时洗)

如果你只想洗全家的内裤,
那就准备三个,一人一个,
如果还想洗袜子,以及妈妈的bra,
(注意,只能洗没有钢圈的)
就多准备几个清洗袋。

我们今天开团的有标准版和家庭版两个版本,
主机相同,
标准版是1只洗涤袋,家庭版是2只洗涤袋,
而且家庭版的三通是带软水过滤功能的,
过滤水源,洗出的衣服更洁净,
尤其适合有孩子的家庭;
而且还能提升机器的使用寿命,更加耐用。
强烈建议入家庭版,
因为洗涤袋一个真心不够啊!
(别问我怎么知道的,后悔……)

但是我掐指一算,
两个洗涤袋也不太够,
所以还给你们单独上架了3色洗涤袋,
分别是:粉色、绿色、橙色,
有需要的朋友可以顺便购买哟。
(洗涤袋30天内发货,介意者慎拍)

觉飞内衣裤洗衣机的洗涤袋,
可以随时取出来清洗晾晒,
完全不用担心会像传统洗衣机那样藏污纳垢。
这样一比,
越发觉得传统洗衣机真心不适合洗贴身衣物。

02
三种清洗模式
智能漂洗,干净如新
除了干净和实用,
对内裤还有一道永恒的追求——
消毒杀菌。

然而杀菌是一件很玄学的事情,
反正效果肉眼不可见,
大多数时候追求的也是一个仪式感。
所以很多人都是从老一辈那听来的,
太阳暴晒就可以杀菌。

但根据觉飞实验室的研究发现,
阳光的穿透力是个硬伤,
一张薄薄的卫生纸就能够阻挡90%以上的紫外线。
更别说一年见不到几次太阳的盆地了,
纯靠晒太阳给内裤消毒,
就跟抽盲盒一样不靠谱。

因此,
觉飞设置了一个强大的杀菌功能——
95℃高温煮洗,
内内取出来都冒着热气,感觉特别安心。

只是感觉当然不行,
根据广州微生物研究所的检测,
觉飞内衣裤洗衣机对引起——
霉菌性阴道炎的白色念珠菌、
金黄葡萄球菌、大肠杆菌……
的杀菌率都高达99.99%。

除了上面介绍的高温煮洗外,
它还有温水速洗和常温净洗模式可选。
高温煮洗——
95度、45分钟,针对细菌、真菌等;
温水速洗——
40度、30分钟,针对汗渍、尿渍,
适合日常清洁;
常温净洗——
常温、35分钟,针对血渍、白带等,
适合女性大姨妈和排卵期期间使用。


每种模式对应不同的需求,
比如给孕妈和宝宝的内裤,
就可以用高温煮洗,
平时的袜子、内衣,
用温水速洗就能很快搞定。

在日常的使用中,
觉飞还有个彩蛋功能让我很惊喜——
智能漂洗,
如果内衣裤漂不干净,
残留了化学洗剂是很伤皮肤的。

它安装了一个灵敏的泡沫探测器,
一旦检测出泡沫过多,
机器就会自动增加漂洗的次数。
这样一来,即使是手滑多放了洗液,
也不用担心残留啦。

“越用用上瘾”,
是很多人使用之后的感悟,
在上市后的短短几个月,
它就迅速蹿红成某红书的新晋网红了,
某宝评价也是好评不断。


▲某红书部分真实用户分享

▲某宝部分好评
最后说下安装和售后问题,
让大家用得舒心。
①安装
购买觉飞内衣裤洗衣机的小伙伴,
都可以享受免费上门安装;
如果动手能力强一些的,
也完全可以跟下面视频自己安装。
需要免费上门安装的小伙伴,
可以通过官方公众号【JOYFACE觉飞】预约。
提交安装表单,
将派送至网点,由网点在工作时间段内联系到您,
并核对具体上门安装时间。
②售后
自签收之日起未拆封安装,
且不影响二次销售,
支持7天无理由退货。
出现质量问题30天内换新,
一年保修,关键零部件三年质保。
关键零部指:
阀门、减速箱套装(含电机)、气泵、外袋。

这是拾遗好物的个人小号【小拾子】
加小拾子微信,拉你入群,有些爆品补货,秒杀清仓等信息,会更及时地通知大家(大号推文次数有限),方便捡漏,哈哈
▼

小拾子微信号
shiyixiaoshizi3


已同步到看一看
写下你的想法